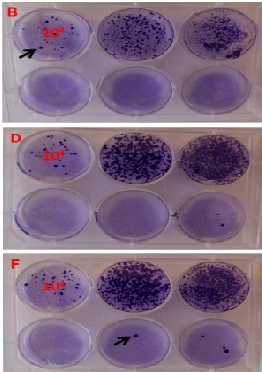
Efficient Lentiviral Transduction of Different Human and Mouse Cells

International Journal of Bioprocessing and Biotechniques

Investigations on Optical and Physical Properties of Sm2O3, Dy2O3 and Eu2O3 Doped Zinc Strontium Bismuth Borate Glasses
Kothandan D, Chandra Babu Naidu K*, Jeevan Kumar R*
International Journal of Bioprocessing and Biotechniques